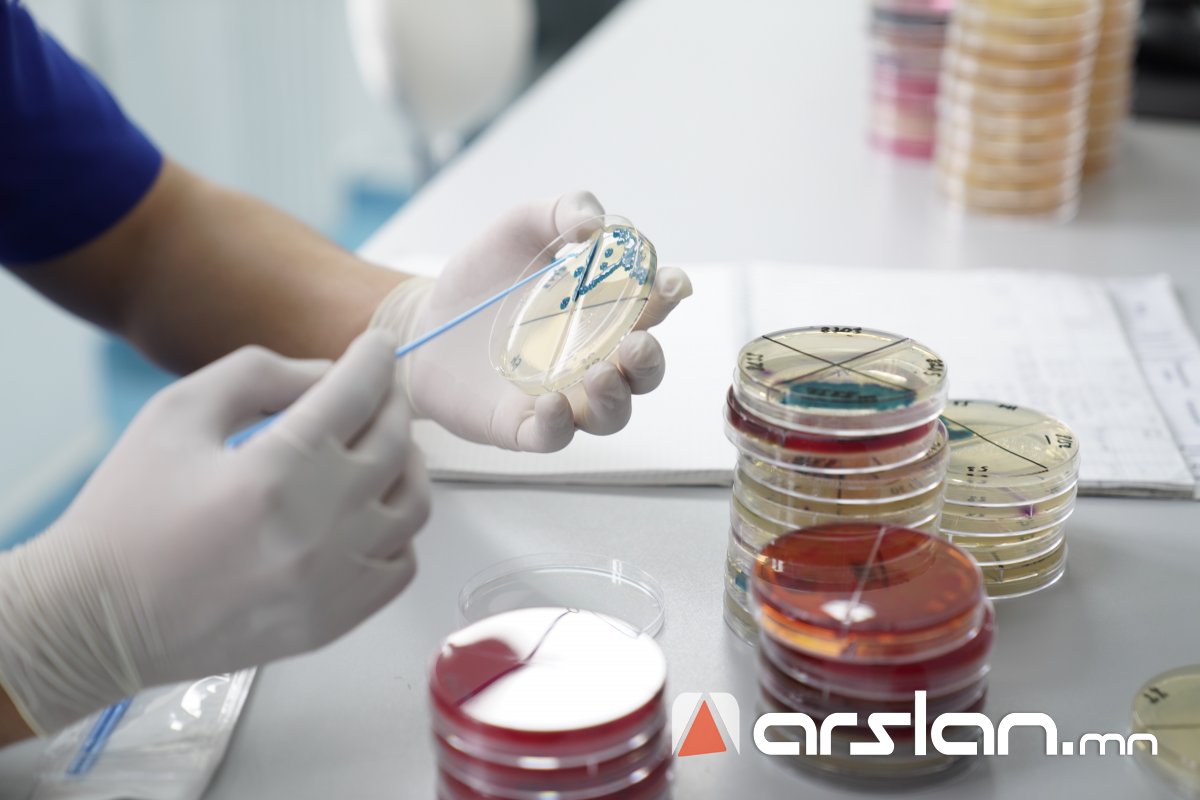

“ЛАБОРАТОРИЙН МЭРГЭЖИЛТНИЙ ДОЛОО ХОНОГ” арга хэмжээнд 350 гаруй лабораторын эмч, мэргэжилтнүүд оролцож байна

Улсын Нэгдүгээр Төв эмнэлгээс санаачлан Монгол Улсад анх удаа зохион байгуулж буй “ЭРҮҮЛ МЭНДИЙН ЛАБОРАТОРИЙН МЭРГЭЖИЛТНИЙ ДОЛОО ХОНОГ” арга хэмжээ өнөөдөр эхэллээ.
Гурван өдөр үргэлжлэх тус арга хэмжээнд 350 гаруй лабораторын эмч, мэргэжилтнүүд оролцож байгаа бөгөөд хуралдаанд нийт 67 эрдэм шинжилгээний ажил, 24 лекцийг эмч, мэргэжилтнүүд тавьж, шилдэгүүдээ тодруулах юм.

Арга хэмжээг нээж, УНТЭ-ийн Ерөнхий захирал Б.Хишигжаргал хэлсэн үгэндээ “Сүүлийн үед анагаахын шинжлэх ухаан хурдацтай хөгжиж байгаагийн цаана далд фронтод таамаглах эмч мэргэжилтнүүд ажиллаж байдаг гэдгийг онцолмоор байна. Аливаа өвчнийг таамаглах, оношлох, үгүйсгэх, менежмент хийх, тарилга тодорхойлох зэрэг бүхий эмнэл зүйн ард нь лабораторийн үйл ажиллагаа байдаг. Сүүлийн үед манай эмнэлэгт шинээр нэвтэрч байгаа эд, эс эрхтэн шилжүүлэн суулгах, ясны чөмөг шилжүүлэн суулгах, элэг, бөөр шилжүүлэн суулгах зэрэг орчин үеийн эмчилгээний шинэ аргуудын гол цөм нь лабораторийн үйл ажиллагаан дээр тогтож байдаг. Тиймээс УНТЭ-ээс лабораторийн эмч мэргэжилтнүүдэд онцгойлон анхаарч ажилладаг.
Манай лабораторийн хэсэг 1936 онд анх байгуулагдсан цагаас хойш өнөөдрийг хүртэл үйл ажиллагаа тасралтгүй явуулж, оношилгооны шинэ арга, технологийг нэвтрүүлэн маш олон өвчнийг оношлох, өдөр тутмын эмнэл зүйн үйл ажиллагаанд оролцохоос гадна улсын хэмжээнд лабораторийн мэргэжилтнүүд бэлтгэж, сургадаг.
Өнөөдөр олон улсад уламжлал болгон зохион байгуулдаг “ЛАБОРАТОРЫН ДОЛОО ХОНОГ”-ийн үйл ажиллагааг Монгол Улсад анх санаачлан зохион байгуулж байгаа манай Лабораторийн тасаг болон Монголын эрүүл мэндийн лабораторийн ажилчдын холбооны хамт олонд талархсанаа илэрхийлье.” гэв.

Эмнэлзүйн эмгэг судлалын нэгдсэн лабораторийн эрхлэгч, АУ-ны доктор Ж.Саранцэцэг энэ үеэр "Анх 1975 онд АНУ-ын лабораторын долоо хоногийг Medical Laboratory Profssional Week буюу Labweek болгон зохион байгуулж, лабораторийн мэргэжилтнүүдийн талаарх олон нийтийн мэдлэг, ойлголтыг нэмэгдүүлэх боломжийг олгодог болсноос хойш 48 дахь жилдээ зохион байгуулж байна. Дэлхийн олон оронд лабораторийн мэргэжилтнүүд жил бүрийн дөрөвдүгээр сарын сүүлийн долоо хоногийг Labweek болгон тэмдэглэж байна. УНТЭ-ийн Эмнэлзүйн эмгэг судлалын нэгдсэн лаборатори/ЭЭСНЛ/ нь Монгол Улсын ууган лаборатори учраас уг арга хэмжээг өөрийн орондоо анх удаа зохион байгуулж байна. Арга хэмжээний үеэр ЭМЯ-ны дэргэдэх лабораторийн мэргэжлийн салбар зөвлөлийн нарийн бичиг А.Баярзаяа “Төрөөс эрүүл мэндийн лабораторийн талаар баримталж буй бодлого, тушаал шийдвэрүүд”, ЭМДЕГ-ын Тусламж, үйлчилгээний багц зохицуулалтын хэлтсийн дарга Б.Баярболд “ЭМДЕГ, Оношийн бүлгийн санхүүжилт-Эрүүл мэндийн лаборатори” сэдвээр, Үндэсний итгэмжлэлийн төвийн БХЗГ-ын хөтөлбөр хариуцсан мэргэжилтэн О.Аззаяа “Монгол Улса мөрдөгдөж буй эрүүл мэндийн лабораториудын ISO стандартууд болон итгэмжлэлийн байдал” зэрэг чухал чухал асуудлуудыг хөндсөн лекцүүд тавьж байна." хэмээлээ.